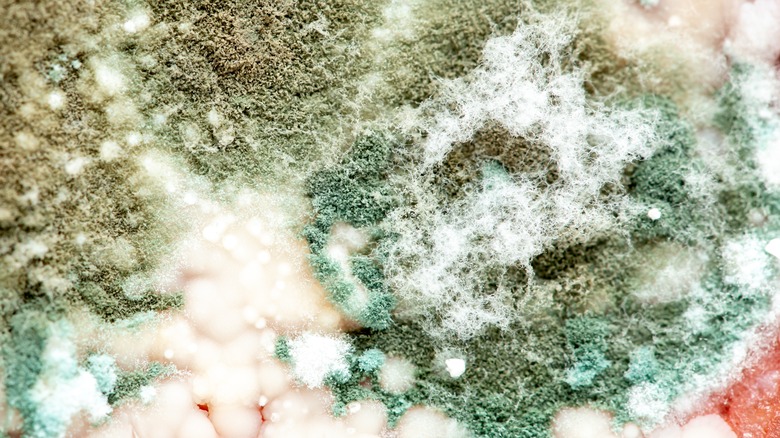

How To Tell If Tuna Salad Has Gone Bad
A classic lunchtime snack or meal, tuna salad is an economical and versatile option. While often made with mayonnaise, you can easily swap in Greek yogurt, hummus, or avocado instead, and add in your choice of crunchy vegetables like celery and onions. You can even take your tuna salad up a notch by adding in some spices, like dill or lemon pepper, or condiments like relish. You can enjoy it in a sandwich, in a lettuce wrap, with some crackers, or even on its own. It's no wonder that many people often make a large batch of it at a time.
As with any leftover food, a big concern is how to tell when the food starts to spoil since eating spoiled food, including tuna salad, can lead to food poisoning. Symptoms of food poisoning from eating bad tuna salad can include vomiting, stomach cramps, and diarrhea. Luckily there are several ways to tell if tuna salad has gone bad, including visual and olfactory clues, as well as knowing how long tuna salad is good for.
How long is tuna salad good for?
According to the USDA, tuna salad, assuming it has been stored properly in the fridge at temperatures below 40 degrees Fahrenheit, is good for 3 to 5 days before it starts to spoil. It's important to refrigerate any leftover tuna salad promptly. Don't let it sit out at room temperature for more than 2 hours (or 1 hour when it's more than 90 degrees Fahrenheit out). Using an airtight container will keep your tuna salad fresher for longer, and also won't let smells in or out. You should also store the tuna salad in the coldest part of your fridge, and not in the door.
Tuna salad doesn't usually freeze well, since it's most commonly made with mayonnaise, which tends to separate when frozen. Crunchy items like veggies can also lose their crunch and become mushy once frozen. If you've made your tuna salad with mayo swaps that can better withstand freezing, such as yogurt or hummus, and minimal other add-ins, then you may be able to extend the life of your tuna salad by freezing it. Canned tuna on its own can typically be frozen for up to 3 months, while yogurt can be frozen for up to 2 months, and hummus for up to 4 months.
Look for visual clues
One way to tell if your tuna salad has gone bad is to look for any changes in appearance. If you see any signs of mold or any green, brown, or dark spots on your tuna salad, then you should toss it out without even tasting it. Although it is possible to salvage some moldy items, like certain hard cheeses, cured meats, and fruits, by cutting off the moldy parts, tuna salad is not one of them, as you may not be able to see the mold spores that could have contaminated the other portions of the tuna salad.
If you see any sign of mold, don't sniff the tuna salad either, as that can cause respiratory issues from inhaling the mold, per the USDA, which also recommends keeping food items covered, even when being served, to prevent mold spores from spreading. So don't leave your tuna salad out uncovered for any length of time, and remember to promptly refrigerate it, ideally in an airtight container.
Use your nose
Spoiling food will often give off a bad or pungent smell, due largely to chemicals produced by spoilage microbes such as bacteria and mold as they grow in food. Tuna and tuna salad tend to have a somewhat strong smell to begin with, so it may be difficult to tell if it's gone bad just using your sense of smell. However, if you open your leftover container of tuna salad and it has an extra fishy, funky, or otherwise off or pungent odor, then chances are, your tuna salad has spoiled and should be tossed out immediately.
Just because the tuna salad doesn't smell off doesn't mean that it hasn't spoiled or gone bad. According to Tufts Now, many microbes that cause food-borne illnesses don't actually give off a noticeable smell when they start growing in food, so don't take the absence of smell as a definitive indicator that your tuna salad is still good.
Other ways to tell
Another way to tell if your tuna salad has gone bad is if it tastes off, or has a slimy or unusual texture. However, it's important to note that if there are any other signs of spoilage present, such as the appearance of mold or a bad smell, do not try tasting the tuna salad. If no other signs are present, try a very small bite of the tuna salad first. If it tastes sour or has an unusual flavor, throw it out.
Lastly, recall that tuna salad is only good for 3 to 5 days when stored properly in the fridge. It's best to label your tuna salad container when storing leftovers so you know when those 3 to 5 days are up. If your tuna salad has exceeded that timeframe, even if there are no other signs of spoilage present, you need to throw it out. While tuna salad is delicious, there's no sense risking food poisoning with tuna salad that has gone bad.